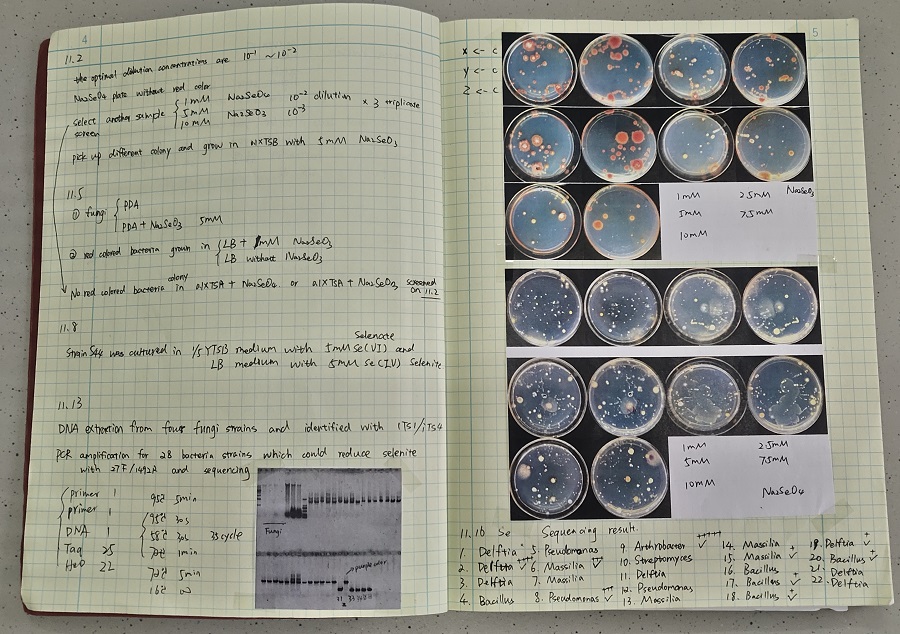

民大风采 ▏彭木博士:勤耕不辍 精业笃行
每学年承担4门本科生课程,每天早上7点到学院直至晚上11点离开,彭木的一天有十几个小时都是在学院度过的。他是走在学术前沿的科研探路人,也是学生眼中的良师益友——他就是生物与食品工程学院的青年博士彭木。2022年,彭木获评湖北省“楚天学者计划”楚天学子,在学习、科研和教学的艰难跋涉中,彭木坚持深耕热爱,享受乐趣,勇担使命,始终以勤勉踏实、奋发图强书写着自己的人生华章。
深耕自己的热爱
“兴趣是最好的老师。”回忆起小时候,彭木告诉记者,他从小就喜欢捉其他小朋友都害怕的昆虫,植物、昆虫之类的自然产物算是他幼时最爱的“玩具”,在初中和高中进一步接触生物学科后,彭木的兴趣日渐浓厚,并慢慢萌生一个志向,要将探索生命奥秘视作人生追求目标。
有了奋斗方向,彭木的大学生活过得很充实。2009年,他考入内蒙古民族大学就读,整个本科阶段,他把大部分时间花在专业课程和实验中。课后闲暇时间,他也没放松,总是找同学探讨交流。生物学是一门以实验为基础的自然科学,本身带有很强的探究性和验证性。

大学时期的彭木
从大一开始,他就主动提出进入实验室学习。因为刚开始对实验技术的不懂,只能做一些不需要技术的活。渐渐地,老师开始给他分配一些小的实验,并加入一些自己的想法去设计实验方案。从进入实验室到现在,每年暑假彭木都没有回过家,有一年寒假主动放弃回家过春节,大年三十和初一都坚守在实验室做实验。他经常说:“哪怕从早到晚除了教室就是实验室,我也不觉得累,因为我乐在其中,我很喜欢科研这个工作。”四年求知若渴的学习让他对生物学研究产生了更加浓厚的兴趣。2013年,他赴东北林业大学攻读硕士。在东林,他深切感受到“强中更有强中手”,也让他更加严格地要求自己。彼时的他,熬夜学习做科研是“必修课”。

彭木在实验室进行实验
“分子生物学是看不见摸不着的,实验中可能百分之八十的工作都是重复操作。”热爱往往能激发一个人更多的科研潜力,当彭木在动手操作时,那些课堂上老师讲解的概念、书本中嵬然不动的原理、作业上沉默的答案,从脑海中呼之欲出,实践升华了理论,也充实了属于他的科研小世界。
彭木相关实验记录
2016年至2021年在东北林业大学攻读博士期间,彭木成功申请博士联合培养,于2018年赴美国俄克拉荷马大学求学两年。在学习的道路上,他专注、认真,不断突破自我,攀上一个又一个学术高峰。
恰是兴趣使然。对生物学纯粹的热爱,激励彭木不断前行。
享受探索的乐趣
彭木主要从事环境微生物研究。他表示,科研道路不是一帆风顺的,“有时候就算有好的想法也不一定能出现好的结果,最重要的是要踏实做事,刻苦钻研”。
遇到特别感兴趣的课题时,除了吃饭和睡觉,彭木会把全部的时间和精力都投入到研究当中。彭木主持的国家自然科学基金项目——生癌肠杆菌JY65缓解水稻NaCl胁迫的分子互作机制研究耗时七年,从实验设计到实验操作基本都是独立一人,现在回想起来,他依旧很享受那种每天全身心地投入、刻苦钻研的状态,他觉得这是一个让研究者很受益的过程。“科学探索本身就存在着很多不确定性,但就是这种对未知的探索与挑战,才是科研工作者最大的动力和快乐。”彭木说。

彭木在修改论文

论文部分截图
回望自己的科研经历,彭木说:“做科研要有自己的想法,也要善于听取别人的建议和意见。初学者要勤与导师沟通,多与团队伙伴交流。只有勇于打破思维定式,才能让自己成为一个研究视野开阔、有创新能力的人。”
担好育人的使命
彭木说:“科研是兴趣,而教书是一种责任,也是一个继续学习和提升自我的过程。”当初之所以选择在高校工作,主要原因之一就是喜欢和学生们在一起。尽管只有两年的教师生涯,彭木有着自己的教学“心法”。在他看来,生物学各个分支学科之间的联系很强,学习生物要注重综合性。因此,课堂上他会有意识地引导学生构建联系性思维。在彭木看来,“这些学生将来不一定要进入微生物这个方向,但希望他们能够在本科阶段打牢基础,少走弯路,学会独立思考和自主学习,在这个过程中找到自己擅长或喜欢的方向。”

彭木在实验室指导学生
如今,彭木主要承担微生物学、遗传学、生物工艺学课程的教学。课堂上,他鼓励学生提问,认为“提出一个问题往往比解决一个问题更为重要”。学生姜智慧说:“实验遇到困难时,我们都积极向彭老师提问,他总是很耐心地为我们答疑解惑。”彭木坚信:“老师与学生之间的互动非常重要,只有调动学生的积极性,才能让他们听课效率更高。”在学生林微渊看来,彭木“是一位讲课风趣幽默,十分负责的老师,语言很有感染力,与学生之间能很好地互动交流,因此课堂气氛也活跃,同学们都很喜欢他”。面对学生的困惑,他耐心指导,循循善诱,给出方向,鼓励他们不断创新。“从他身上,我们学到的不仅是专业知识,还有不忘科研初心、坚守学术道德的精神以及积极进取、认真负责的态度。”学生向智文说。

彭木的课堂
对彭木而言,培养学生的同时也是在提升自己。当他谈到点燃学生们探索微生物的兴趣、经自己指导的学生学有所获时,欣慰之情溢于言表。努力成为学生的良师益友,为学生成长“护航”,彭木甘之如饴。
桃李不言,下自成蹊。彭木以扎实学识和开阔格局作为基石,用满腔热情和积极态度拥抱科研,将热血化作春雨,滋润学生心灵,在科研育人路上播种希望,彭木是桂花园里一道亮丽的风光。





